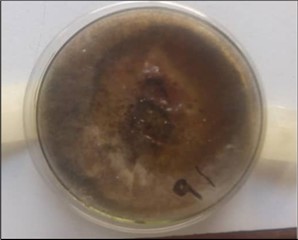

Production of biodegradable polymer via graft copolymerization of gum Arabic and polyethylene glycol
Abstract
The increasing demand for environmentally-friendly materials has led to a surge in research on the production of biodegradable polymers. In this study, we investigate the synthesis of a biodegradable polymer by graft copolymerization of gum Arabic (GA) and polyethylene glycol (PEG). GA, a natural polysaccharide and PEG, a synthetic water-soluble polymer, were used as the backbone and graft monomer, respectively. The graft copolymerization was carried out using benzoyl peroxide as an initiator and performed under nitrogen atmosphere. The resulting polymer was characterized by Fourier transform infrared (FTIR) spectroscopy, Xray diffraction (XRD), thermogravimetric analysis (TGA), and scanning electron microscopy (SEM). The FTIR spectra confirmed the formation of the graft copolymer, and TGA analysis showed that the copolymer had higher thermal stability than GA. The DTA thermograms indicated two thermal events. The evaporation of water and organic polyethylene glycol components was measured, and the first mass loss was due to the loss of adsorbed and structural water in the gum Arabic, which occurred between 31.87 and 180°C, while the second, corresponding to the pyrolysis of polyethylene glycol functional groups and polysaccharide decomposition, resulted in a 70% mass loss. SEM morphological analysis of gum Arabic showed aggregates of high irregularity in particle shape. The cracks and holes obtained in the Gum Arabic micrograph disappeared from the new gum Arabic-graft-polyethylene glycol, leaving a smooth surface with scattered particles in the image, which was due to the grafting copolymer. From the XRD patterns, the percentages of the amorphous and crystalline phases were determined. The results show that gum Arabic has a 78% degree of crystallinity, whereas gum Arabic-graft-polyethylene glycol has the lowest value of 51%. Biodegradation activity was observed using the fungus Aspergillus flavus on different days on gum Arabic-g-polyethylene glycol. The results clearly showed inhibition zones with a change in the state of the copolymer from solid to liquid from days 8 to 14. These results indicate that the GA-PEG copolymer has potential as a biodegradable material for use in various applications, such as packaging, agriculture, and medical industries.
Author Contributions
Copyright © 2023 Rifkatu Kambel Dogara, et al.
This is an open-access article distributed under the terms of the Creative Commons Attribution License, which permits unrestricted use, distribution, and reproduction in any medium, provided the original author and source are credited.
Competing interests
The authors have declared that no competing interests exist.
Citation:
Introduction
Over the years, major interest has shifted to the use of synthetic polymers owing to their ease of conversion and wide range of applications in various fields. Petroleum-based polymers have historically been the largest consumers of plastics and are widely used worldwide. As these polymeric materials are lightweight, inexpensive, and corrosion-resistant, large volumes are produced each year, and a large portion of the plastic produced each year is used to make disposable packaging or other short-lived products that are discarded within a year of manufacture12. Synthetic polymers are generally made from non-renewable petroleum-based resources, which are non-biodegradable and create global environmental problems3. This is because approximately 4 percent of annual petroleum production is converted directly into plastics from petrochemical feedstock. Because the manufacture of plastics also requires energy, its production is responsible for the consumption of a similar additional quantity of fossil fuels. Most plastics produced from petrochemical resources emit high levels of greenhouse gases, which have a negative environmental impact. Increasing environmental awareness, together with the limitation of fossil resources, has led to the formation of a market for bio-based plastics, which combine the benefits of a reduced carbon footprint during production with increased resource efficiency or even improved material properties2.
Biodegradable polymers widen the scope of waste control and treatment options over conventional fossil fuel polymers, which is corroborated by life cycle assessments1. Polyethylene glycol (PEG) is the most commonly used petroleum-based polymer for packaging applications. It is extremely difficult for PE or other petroleum-based polymers to be biodegraded after disposal on land or on the coast, thus creating varying levels of contamination. To address this problem, much attention has been paid to the development of biodegradable polymers from renewable resources in recent years, which is driven by global environmental awareness18. Bioplastics are a family of materials with different properties and applications that can be bio-based, biodegradable, or both. Biodegradable plastics are made from renewable or non-renewable sources that are completely degraded in the environment through a thermochemical process into CO2, methane, water, biomass, and inorganic compounds that microorganisms can easily mineralize4. The annual production of bioplastics is relatively low, accounting for less than one percent of the almost 360 million tons of plastic produced per year7. In 2019, their production was 2.11 million tons (of which 44.5% were bio-based or non-biodegradable bioplastics and 55.5% were biodegradable bioplastics)7. Moreover, by 2024, the production of bioplastics is expected to reach approximately 2.43 million tons7.
Biodegradable polymers can be classified into two classes based on their synthesis: synthetic and natural polymers. They are derived from petroleum or other biological resources.4. Cellulose is a natural polymer, an organic polysaccharide with the formula (C6H10O5)n, consisting of a linear chain of several hundred to over ten thousand 1,4-linked D-glucose units14.
Natural polysaccharides have received increasing attention owing to their advantages over synthetic polymers, such as non-toxicity, biodegradability, and low cost. The modification of polysaccharides by graft copolymerization improves the properties of natural polysaccharides17. Grafting improves the characteristic properties of the backbone. Such properties include water repellence, thermal stability, flame resistance, dyeability, and resistance to acid-base attack and abrasion. Polysaccharides are the most abundant class of biopolymers and are obtained from animals, plants, microbes, and algae6. Monosaccharides are monomer units of polysaccharides. Polysaccharides are highly stable, renewable, nontoxic, intrinsically biodegradable, relatively cheap, and hydrophilic in nature owing to the presence of functional groups such as hydroxyl and carboxylic acids, and it is these functional groups in polysaccharides that offer the floor for their modification6. Polysaccharides are the most abundant natural organic materials, and polysaccharide-based graft copolymers are of great importance and widely used in various fields17. Gum Arabic is a non-toxic polysaccharide derived from the exudate of the Acasia seyal tree. Gum Arabic has a complex structure consisting of L-arabinose, D-galactose, L-rhamnose, D-glucuronic acid, and a small fraction of nitrogen-containing substances. Gum Arabic has high water solubility, behaves as a natural coolant, and aids in the degradation of the material to which it is added16. Recently, non-food applications of tree gums in bio-nanotechnology, environmental, and biomedical fields have been comprehensively reviewed. Gum Arabic, a tree gum exudate, possesses highly divergent structures and harbors a core consisting of -(13) galactose residues with extensive branching at the C-3 and C-6 positions. Gum Arabic is primarily composed of arabinose, galactose (both monosaccharide sugars), rhamnose (a deoxy sugar), and glucuronic acid (a glucose-derived sugar). Gum Arabic has been used for the fabrication and stabilization of metal and metal oxide nanoparticles, carbon nanotubes, and quantum-dot nanocolloid materials. Recently, investigations into the fabrication of gum Arabic fibers via electrospinning in aqueous media have been conducted13.
Copolymerization modifies the symmetry of the polymeric chain and modulates both intramolecular forces and properties, such as the glass transition temperature, crystallinity, solubility, elasticity, permeability, and chemical reactivity, within wide limits. Graft copolymers are prepared by polymerizing a monomer in the presence of a polymer with a different backbone chain11. Graft copolymerization of vinyl acetate onto gum Arabic in an aqueous medium was studied using benzoyl peroxide in the presence of polyvinyl alcohol9. Defining graft copolymers as "graft copolymers consist of a polymer backbone with lateral covalently linked side chains," Both the backbone and the side-chain polymers can be homopolymers or copolymers. Graft copolymers are polymers composed of molecules with one or more blocks of species connected to the main chain as side chains, with constitutions or configurational features that differ from those of the main chain7. The graft copolymers were prepared by polymerizing a monomer in the presence of a polymer with a different backbone chain. Grafting results in the retention of desirable properties of the base polymer and the incorporation of favorable properties in the grafted polymer11. This work focuses on the development of a biodegradable polymer through the graft copolymerization of gum Arabic, a natural polysaccharide, with polyethylene glycol 600.
Methodology
Chemicals and reagents
Materials: distilled water, polyethylene glycol 600 MW, benzoyl peroxide, sulfuric acid (Zayo Sigma Aldrich), methanol (Zayo Sigma Aldrich), and isopropanol (Zayo Sigma Aldrich). Viscometer (£ T$ A).
Sample collection
Gum Arabic was purchased from Gombe's main market in Gombe, Nigeria. It was purified by dissolving it in distilled water for three days and then filtering.
Graft copolymerization
Gum Arabic was successfully copolymerized with polyethylene glycol using the process described below. The grafted copolymer was preceded by varying (1g, 2g, 3g, 4g, and 5g) the concentration of gum Arabic in polyethylene glycol using the quantity of the initiator. This was done to achieve the best reaction conditions for grafting the copolymer gum Arabic with polyethylene glycol. The polycondensation reaction was initiated by addition of benzoyl peroxide. Gum Arabic (2g) was dissolved in 20 ml of distilled water, and 4 ml of polyethylene glycol was added to the solution. The beaker was placed in a water bath at 70°C and mixed for minutes min. 0.02 g of benzoyl peroxide was transferred to the solution at 70°C, and the reaction was allowed to proceed on an equipped heated source at a constant temperature of 70°C for 2h. Excess isopropanol (150 mL) was then added to the reaction mixture to precipitate the polymer. The polymer was then filtered and air-dried for 24 hours. The polymer was weighed, and the total weight of the polymer was recorded.
The backbone of the polymer chain was isolated by treating the polymer with 5 mL of dilute sulfuric acid for 24 h at room temperature. The mixture was then poured into 100 mL of methanol to precipitate the polymer. The precipitate was allowed to dry for 24 hours. The precipitate was dissolved in 5 ml of dilute sulfuric acid, and the average molecular weight was determined by determining the viscosity of the solution.
Biodegradation
Arabic-graft polyethylene glycol (10g) was placed in Petri dishes containing a medium containing 1 mg of Aspergillus flavus. The Petri dishes were then covered in a drawer at 37 °C in an incubator for 72 hours. Degradation activity was recorded after 72 and 14 days, respectively.
Characterization
FTIR spectra were recorded using a Shimadzu FTIR-8400S Fourier transform spectrophotometer. Phenom World X region SEM was used to characterize the surface morphology. Thermogravimetric analysis (TGA) was performed using a thermogravimetric analyzer (Perkin Elmer, TGA 4000). The structural characteristics of the Arabic-g-polyethylene glycol and gum Arabic particles were measured using an X-ray diffractometer operated at 0 kV and 0 mA (Rigaku-binary). The samples were scanned at two angles with a CuK radiation source (k = 1.54060 ) at a 240.0 goniometer radius of a 91.00 distance focus].
Results and Discussion
Fourier Transform Infrared Spectroscopy
Figure 1 depicts the FTIR spectra obtained for gum Arabic and gum Arabic-graft-polyethylene glycol. The results show that the 3402.54 cm-1 absorption band represents the presence of the O-H group present in both the gum Arabic and the polyethylene glycol. Another 2922.97 cm-1 indicated the presence of sugar, galactose, abinose, and rhodamine, as well as the presence of alkane C-H stretch and aldehyde C-H stretch. The glucuronic acids have specific vibrations, such as the bands at 1411.94 cm1 and 1301.99 cm1, due to C=O symmetric stretching and -OH bending modes, respectively. 1354.07 cm-1 as a result of C-H bend vibration, as well as a combination band of O-C-H and C-O-H deformation ranging from 1450.52 cm-1 to 3154.07 cm-1. Then the in-plane C-H and O-H deformations went from 1249.91 cm-1 to 954.80 cm-1. 1728.28 cm-1 characteristic band of C=O stretching, mode due to carboxylic acid group for gluconic acid from 1107.18 cm-1 to 596.02 cm-1.
Figure 1.FTIR spectrum of Gum Arabic-graft-polyethylene glycol
Scanning Electron Microscopy
Plate I and Plate IIshow SEM images of gum Arabic-graft-polyethylene glycol and gum Arabic. Plate I and Plate II depict the surface morphologies of gum Arabic and gum Arabic-graft-polyethylene glycol. The grafting of gum Arabic and polyethylene glycol, a biopolymer and a synthetic polymer, respectively, is clearly visible in the SEM micrograph of gum Arabic-g-polyethylene glycol grafting. Gum Arabic's morphological study revealed highly irregular aggregates, and the micrograph revealed the edges of the unevenly shaped particles16. Owing to the grafting copolymer, the cracks and holes in gum Arabic-graft-polyethylene glycol vanished, leaving a smooth surface with scattered particles in the image.
Plate I.Scanning electron microscopy of Gum Arabic-graft-polyethylene glycol
Xray Diffraction Analysis
The XRD micrographs obtained for gum Arabic-graft-polyethylene glycol and gum Arabic are presented in Figure 2and Figure 3, respectively. The XRD pattern shows a decrease in the crystallinity of the graft copolymer gum Arabic-graft-PEG. The results show a slight shift in the peak of gum Arabic-g-polyethylene glycol compared to that of pure gum Arabic, indicating the creation of a graft copolymer15. The XRD pattern of gum Arabic-graft-polyethylene glycol showed a broad peak at 8.47° with a relative intensity of 5.3, conforming to its amorphous nature, whereas the peak obtained for gum Arabic at 8.52° with a relative intensity of 1.5 has a crystalline nature16. The pattern of gum Arabic consisted of broad amorphous peaks at 8.52° and 29.54° and sharp crystalline peaks at 34.21°, 38.00°, 39.76°, 42.67°, 44.23°, 64.48°, and 68.84°. In Figure 2, the X-ray pattern of gum Arabic-graft-polyethylene glycol shows shape peaks at diffraction angles of 8.47°, 30.83°, 34.22°, 38.06°, and 44.27°, indicating a decrease in the crystalline phase of the graft copolymer.
Figure 2.XRD pattern of Gum Arabic
In figure 3, some gum Arabic peaks vanished due to graft copolymerization between gum Arabic and polyethylene glycol8. The degree of crystallinity (Xc) was determined by further investigating the percentage of amorphous or crystalline materials. Based on the study by15, Xc was determined from the XRD data of gum Arabic-graft-polyethylene glycol and gum Arabic. The equation was used to calculate the results, and the lower the Xc value, the more amorphous the material.
Xc = × 100
Figure 3.XRD pattern of Gum Arabic-graft- polyethylene glycol
where Tc is the total area under the graph of the crystalline peak, and Ta is the total area under the graph of the amorphous peak. The results show that gum Arabic has a 78 percent degree of crystallinity (Xc), whereas gum Arabic-graft-polyethylene glycol has the lowest value of 51%. Shown in Figure 4
Figure 4.XRD pattern (superimposed) of Gum Arabic and Gum Arabic-graft- polyethylene glycol
Thermogravimetric Analysis
Thermogravimetric Analysis (TGA) thermograms obtained for gum Arabic-graft-polyethylene glycol, and gum Arabic are shown in figure 5. Thermogravimetric analysis was performed on gum Arabic-graft-polyethylene glycol samples in a nitrogen atmosphere. The thermograms show the thermal stability data and thermal behavior of gum Arabic-graft-polyethylene glycol. The gum Arabic-graft-polyethylene glycol was heated from 30.00oC to 950.00oC at a rate of 10.00oC per minute; as a result, two mass loss events were recorded. The first mass loss is due to the loss of adsorbed and structural water in gum Arabic and occurs between 31.87°C and 180°C, as described by other authors5, or can be attributed to the evaporation of water and organic components such as polyethylene glycol10. Polysaccharide decomposition was related to the second mass loss with an onset temperature of approximately 270°C, which resulted in a 70% mass loss and was described by a weight loss onset of 270°C and a maximum oxidation temperature of 480°C. This corresponds to the pyrolysis of polyethylene glycol functional groups10. Therefore, the copolymer exhibited improved thermal stability.
Figure 5.Thermal stability of gum Arabic-graft-polyethylene glycol and gum Arabic
Biodegradation
Plate, Plate IV, and Plate V show the biodegradation activity of Aspergillus flavus on different days in gum Arabic-graft-polyethylene glycol. Plate III shows day one incubation at room temperature with no visible activity. The image obtained for plate IV clearly shows inhibition zones as the copolymer state changes from solid to liquid. Plate V showed an increase in the inhibition zone and a reduction in the liquid volume.
Plate III.First day of incubation of gum Arabic-graft-polyethylene glycol before degradation
Plate IV.5 days of biodegradation activity of Rhizopous Oryzea on gum Arabic-graft-polyethylene glycol
Plate V.14 days of biodegradation activity of Rhizopous Oryzea on gum arabic-graft-polyethylene glycol
Conclusion
In this study, we successfully synthesized a biodegradable polymer through the graft copolymerization of gum Arabic and polyethylene glycol. The resulting copolymer was characterized by various analytical techniques, including FTIR, TGA, and SEM. The results showed that the copolymer had improved thermal stability and a porous structure, which makes it a promising material for various applications. The biodegradability of the copolymer was investigated in this study by exposing it to Aspergillus flavus for 8 to 14 days, the gum Arabic-graft-polyethylene glycol copolymer clearly exhibited inhibition zones with a change in the state of the copolymer from solid to liquid. Therefore, gum Arabic-graft-polyethylene glycol exhibited more biodegradable polymer properties. From the XRD pattern, the crystallinity was observed to have decreased from 78% to 51% in the amorphous phase. Nonetheless, this study provides a basis for further exploration of GA-PEG copolymers as a sustainable alternative to traditional non-degradable polymers. The production of biodegradable polymers through graft copolymerization can contribute to the development of a more sustainable and eco-friendly material industry.
Conflict of interest
No conflict of interest declared.
Acknowledgements
This study was supported by the Department of Chemistry, Gombe State University, National Research Institute for Chemical Technology, Zaria, and Department of Science Laboratory Technology, Federal College of Forestry, Jos.
References
- 1.A, O, D O Rotimi, O P Abioye, C et al. (2019) . Review of the Development of Biodegradable Plastic from Synthetic Polymers and Selected Synthesized Nanoparticle Starches. Journal of Physics: Conference Series 1378, 1-11.
- 2.Andreeßen C, Steinbüchel A. (2019) Recent developments in non-biodegradable biopolymers: Precursors, production processes, and future perspectives. , Applied Microbiology and Biotechnology 103, 143-157.
- 3.A S Chandure, S B Ganesh, S U. (2014) . , Synthesis, Characterization, and Biodegradation Studies of Poly(1,4-cyclohexanedimethylene-adipate-carbonate). Journal of Polymers 2014, 1-11.
- 4.Čolnik M, K H Maša, Mojca Š, Željko K. (2019) Biodegradable polymers, current trends of research and their applications, a review.
- 5.Daoub R M A, H E Aarif, Misni M, A H Elfatih, E O Mohammed. (2018) Characterization and functional properties of some Natural Acacia gums. , Journal of the Saudi Society of Agricultural Sciences 17, 241-249.
- 6.P N Dave, Gor A. (2018) Natural Polysaccharide-Based Hydrogels and Nanomaterials: Recent Trends and Their Applications. Handbook of Nanomaterials for Industrial Applications. , DOI: 10-1016.
- 7.Folino A, Aimilia K, S C Paolo, Dimitrios K. (2020) . , Biodegradation of Wasted Bioplastics in Natural and Industrial Environments: A Review. Sustainability 12, 1-37.
- 8.Hassani A, Syed M, H E, A H Siti, A H Hamad et al. (2020) Formulation, Characterization and Biological Activity Screening of Sodium Alginate-Gum Arabic Nanoparticles Loaded with Curcumin. , Molecules 25(2244), 1-21.
- 9.Inegbedion F, V U Okojie, Egharevba F. (2016) Graft Copolymerization of Vinyl Acetate on Gum Arabic. , Effect of Amount of Substrate. Research & Reviews in Polymer 7(3), 1-4.
- 10.Jayaramudu T, M R Gownolla, Kokkarachedu V, Gangireddygari V S R, R A Babul et al. (2016) Preparation and characterization of poly (ethylene glycol) stabilized nano silver particles by a mechanochemical assisted ball mill process. , Journal of Applied Polymer Science 133(7), 43027.
- 11.Kumar D, Jyoti P, Vinit R, Pramendra K. (2017) A Review on the Modification of Polysaccharide through Graft Copolymerization for Various Potential Applications. , The Open Medicinal Chemistry Journal 11, 109-126.
- 12.Kwesiga D. (2018) Strategies for Managing Plastic Waste from Construction and Manufacturing Projects. , Rwanda Journal of Engineering, Science, Technology and Environment 1, 1-9.
- 13.Padil V V T, Chandra S, Stanisław W, Miroslav C, Seema A et al. (2019) Bioplastic Fibers from Gum Arabic for Greener Food Wrapping Applications. ACS Sustainable Chemistry & Engineering,7: 5900-5911.
- 14.Rajeswari S, Prasanthi T, Sudha N, R P Swain, Panda S et al. (2017) Natural polymers. A recent review. , World Journal of Pharmacy and Pharmaceutical Sciences. Vol 6, Issue 8.
- 15.M A Ramlli, M A, Isa M I N. (2017) Characterization of Polyethylene Glycol Plasticized Carboxymethyl Cellulose-Ammonium Fluoride Solid Biopolymer Electrolytes. AIP Conference proceedings 1826(1), 020001-02006.
- 16.M N Renjini, Bindhu B, V L Reena. (2020) A polymer blend from Gum Arabic and Sodium Alginate-preparation and characterization. , Journal of Polymer Research 154(27), 1-7.

